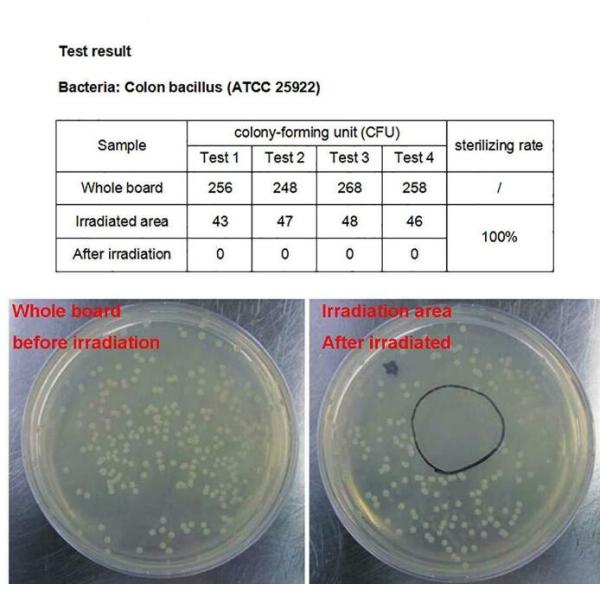

| Sign In | Join Free | My polstate.com |
|
Brand Name : DELI
Model Number : DLWS-UVC-24
Place of Origin : CN
MOQ : 1
Price : netoation
Payment Terms : T/T, Western Union, paypal
Supply Ability : 10000
Delivery Time : 3-5days
Packaging Details : normal safe packaged
Voltage : DC 24V
Current : 40±2mA
Environment temperature : ≤55℃
UVC LED Luminous Power : 2.0-3.0mW
Insulation and voltage resistance : AC 1500V, 50Hz / 1min
Lifespan : >10,000H
Dominant Wavelength : 270nm-285nm
Cut-out Hole : 27.5mm
Optical and Electrical Characteristics @TJ=25℃
| Item | symbol | condition | Min | Average | Max | Unit |
| Angle | 2θ1/2 | 24DC | --- | 120 | --- | deg |
| Output | P | 24DC | --- | ≥2 | --- | mW |
| Half-wave width | Δλ | 24DC | 8 | 11.5 | 12 | nm |
| Peak Wavelength | λP | 24DC | 265 | 275 | 285 | nm |
| 1. High performance: Kill 99.99% of harmful bacteria with UV light in seconds. |
| 2. DIY Water Sanitizer solution: Clean water by installing a UVC LED module. |
| 3. Environmental friendly: Chemical-free ultroviolet lighting source. |
| 4. Long serving life: Nearly 10000 hours of working life. |
| 5. Third party tested: CE, RoHS certificates. |
| 6. Instant start. |
Test Method:
| 1. Turn on the UVC LED device. |
| 2. Make a bacteria smear of 0.1ml colon bacillus liquid with the density of 3000cfu/ml. |
| 3. Expose the smear under the UVC LED device for 5 minutes with a distance of 1 cm. |
| 4. Get the test result and calculate the disinfection rate. |
Notes:1. SMD diodes should not be exposed in the air. It may affect its working life.2. Use the LED diode in 1 month when it is unsealed.3. SMD diode storage temperature:10-55℃; Humidity<65%RH;It is suggested the SMD diodes should be used in one year.4. The SMD diodes should be put into antistatic bags when it’s in stockbecause LED diode is electrostatic sensitive.5. Deep UVC light may hurt eyes or skin.It is suggested to take countermeasures before exposing to UVC light. |

Deli electronics tehcnology co ltd
www.icmemorychip.com
www.uvc-led.net
Email:sales3@deli-ic.com
Skype:hkdeli881
sales: VIVI-CHEN
|
|
Water Sterilizer UVC LED Lamp Module DC 24V With Cable XH2.54 2P Terminal Images |